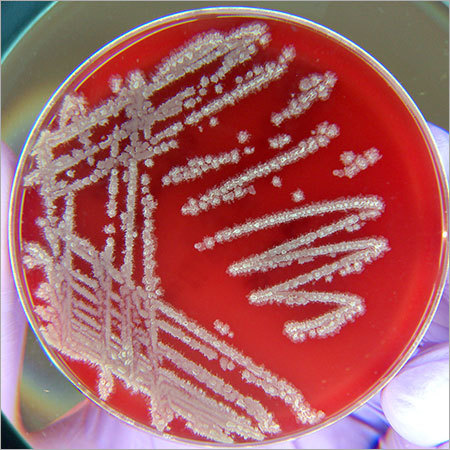
<p><strong>Common Name</strong>: <span style="background-color: transparent; font-family: "Helvetica Neue", sans-serif;"><em><span>Bacillus licheniformis</span></em></span></p><p><strong>Parts Used</strong>: Whole organism; endospore</p><p><strong>Use/s</strong>: Antimicrobial and antifungal; source of probiotics</p><p><strong>Major Metabolites</strong>: Bacitracin, lichenysin (non-ribosomal peptides); <strong><u>bacteriocins</u></strong></p>

[104] Exam 2 Tabulation
1/145
There's no tags or description
Looks like no tags are added yet.
Name | Mastery | Learn | Test | Matching | Spaced | Call with Kai |
|---|
No analytics yet
Send a link to your students to track their progress
146 Terms
Andrographis paniculata (Burm. f.) Wall. ex Nees (Acanthaceae)
Common Name: Green chiretta, Serpentina/Sinta
Parts Used: Aerial parts, roots, dried leaves, fresh leaves, whole plant
Use/s: Hepatoprotection, respiratory infections, anti-inflammatory, anthelmintic
Major Metabolites: Andrographolide (diterpenoid), flavonoids, polyphenols

Agaricus subrufescens Peck (Agaricaceae)
Common Name: Almond mushroom
Parts Used: Whole mushroom
Use/s: Anti-cancer, Anti-tumor, anti-angiogenic, anti-metastatic, anti-genotoxicity, antimicrobial
Major Metabolites: Agaritine, steroids (blazein); glucans

Amanita muscaria (L.) Lam. (Amanitaceae)
Common Name: Fly agaric, muscaria
Parts Used: Whole mushroom
Use/s: Religious rituals, insecticide
Major Metabolites: Muscarine (alkaloid), muscimol

Allium cepa L. (Amaryllidaceae)
Common Name: Onions, sibuyas
Parts Used: Bulb, roots
Use/s: Colds, coughs, fever; cardiovascular health, anti-diabetic, anti-asthmatic (respiratory health), antimicrobial and antifungal
Major Metabolites: Organosulfur compounds, quercetin (flavonoids), saponins, fructans

Allium sativum L. (Amaryllidaceae)
Common Name: Garlic, bawang
Parts Used: Bulb
DOH Use/s: Hypertension, cholesterol-lowering, toothaches
Other Use/s: Fevers and respiratory disorders, anti-bacterial, anti-fungal, etc.
Major Metabolites: Organosulfur compounds, flavonoids, saponins, fructans

Anacardium occidentale L. (Anacardiaceae)
Common Name: Cashew tree / kasoy
Parts Used: Seed, Fruit, Leaves
Use/s: Diabetes, infections, skin conditions, diarrhea
Major Metabolites: Flavonoids, polyphenolics, tannins, alkaloids, etc.; anacardic acid

Mangifera indica L. (Anacardiaceae)
Common Name: Mango
Parts Used: Peel, pulp, seeds, leaves
Use/s: Hypoglycemic, anti-cancer, anti-oxidant, GIT issues (diarrhea)
Major Metabolites: Tannins, phenolic acids, flavonoids; mangiferin (xanthones; polyphenol)

Annona muricata L. (Annonaceae)
Common Name: Soursop, guyabano
Parts Used: Fruits, seeds, leaves, stem bark, roots
Traditional Use/s: Antiseptic, anti-hypertension
Use/s: Skin and respiratory diseases, fever, bacterial infections, diabetes, cancer
Major Metabolites: Alkaloids, flavonoids, tannins; annomuricins and annonacin (acetogenins)

Annona squamosa L. (Annonaceae)
Common Name: Sugar apple, sweetsop, custard apple
Parts Used: Fruit (pulp, peel, pericarp), seeds, leaves, bark, roots, stems, and twigs
Use/s: Boils, epilepsy, fever, diarrhea, haemorrhage, and tumours, venereal diseases, etc.
Major Metabolites: (Isoquinoline) alkaloids, diterpenes, phenolics, terpenoids, etc.; squamocin, bullatacin (acetogenins)

Apium graveolens L. (Apiaceae)
Common Name: Celery
Parts Used: Seeds, leaves, stems, roots, tubers
Traditional Use/s: Cardiovascular diseases, stomach pain, jaundice, rheumatoid arthritis, gout
Medicinal Use: Antibacterial, antifungal, anti-inflammatory, antioxidant, diuretic, urinary antiseptic
Major Metabolites: Apigenin (flavonoids); fatty acids, alkaloids, steroids, glycosides, vitamins A and C

Centella asiatica L. Urb. (Apiaceae)
Common Name: Spadeleaf, Asiatic Pennywort, Gotu Kola
Parts Used: Leaves, flowers, and stalks.
Use/s: Skin diseases (psoriasis and eczema), antioxidant, wound healing, mental enhancement, renal difficulties
Major Metabolites: Pentacyclic tetraterpenoids, triterpenoid glycoside; asiaticoside, madecassoside (triterpenoid saponins)

Alstonia scholaris (L.) R. Br. (Apocynaceae)
Common Name: Dita, Devil's tree
Parts Used: Latex, bark, and leaf
Use/s: Inflammation, chronic skin problems, galactagouge, anti-cancer, anti-hypertension, anti-inflammatory, analgesic, antidiabetic, nephro/neuroprotective
Major Metabolites: Triterpenes, flavonoids, phenolics; alstonine, scholaricine (indole alkaloids)

Nerium oleander L. (Apocynaceae)
Common Name: Adelfa, oleander, rose laurel, rosebay
Parts Used: Leaves and flowers
Use/s: Alopecia and leprosy (skin disorders), epilepsy, hemorrhoids, venereal diseases, antioxidant, anticancer, antimicrobial, antiparasitic, etc.
Major Metabolites: Oleandrin (cardiac glycosides); cardenolides, pregnanes, pregnane glycosides, triterpenoids, steroidal alkaloids

Plumeria rubra L. (Apocynaceae)
Common Name: Kalachuchi
Parts Used: Bark, latex, leaves
Use/s: Rituals; cardiovascular conditions, anti-inflammatory, antibacterial, antioxidant, antimutagenic, antimycotic, antipyretic/antinociceptive, anticancer, anxiolytic, antiulcer, antidiabetic
Major Metabolites: Iridoid glycosides, flavonoids; steroids, alkaloids, phenolic compounds, terpenoids

Tabernaemontana pandacaqui Poir (Apocynaceae)
Common Name: Pandakaki
Parts Used: Leaves, root, stem, and bark
Use/s: Stomach and intestinal affections; induce menstruation, hasten parturition, reduce swellings
Major Metabolites: (Indole) alkaloids, terpenoids, phenols, tannins

Catharanthus roseus (L.) G. Don (Apocynaceae)
Common Name: Madagascar periwinkle
Parts Used: Stem, leaves
Use/s: Anti-cancer, hypoglycemic, emetic
Major Metabolites: Vincristine, vinblastine (alkaloids)

Panax ginseng C.A. Meyer (Araliaceae)
Common Name: Asian Ginseng
Parts Used: Roots
Use/s: Adaptogen, calming (as tonic), immune-modulating, anti-fatigue, cognitive enhancement
Major Metabolites: Ginsenosides (triterpenoid saponins)

Nypa fruticans Wurmb. (Arecaceae)
Common Name: Nipa
Parts Used: Roots, leaves, stems, wood, sap, fruit
Use/s: Asthma, fever, toothaches; antioxidant, antibacterial, anti-inflammatory, antidiabetic, analgesic, anticancer
Major Metabolites: Alkaloids, flavonoids, polyphenols, tannins, saponins, steroids

Areca catechu L. (Arecaceae)
Common Name: Betel Nut Palm, Bunga, Areca nut
Parts Used: Dried ripe nut
Traditional Use/s: Stimulant, laxative/purgative
Medicinal Use/s: Antiparasitic, antioxidant, analgesic, anti-inflammatory, antibacterial, antifungal, lipid & blood glucose management
Major Metabolites: Arecaine, arecoline, arecaidine (alkaloids); triterpenoids, tannins, flavonoids

Cocos nucifera L. (Arecaceae)
Common Name: Coconut, Coconut Palm
Parts Used: Husk, pulp, flower, water, roots
Traditional Use/s: For diarrhea, amenorrhea, venereal diseases, etc.; oil for hair loss and wound healing
Medicinal Use/s: anthelminthic, anti-inflammatory, antinociceptive, antioxidant, antifungal, antimicrobial, antitumor, etc.
Major Metabolites: Alkaloids, tannins, flavonoids, triterpenes, steroids, alkaloids, triterpenes; lauric acid (fatty acids)

Aloe vera (L.) Burm.f. (Asphodelaceae)
Aloe barbadensis Miller (Asphodelaceae)
Common Name: Aloe vera, sabila
Parts Used: Mucilaginous gel
Use/s: Laxative, emollient, moisturizer, alopecia; anticancer, antioxidant, antidiabetic, bone protection, cardioprotective, etc.
Major Metabolites: Aloin and emodin (anthraquinone glycosides), acemannan; aloesin (chromone), aromatic polyketides, tetracyclines

Artemisia vulgaris L. (Asteraceae)
Common Name: Mugwort
Parts Used: Aerial parts
Use/s: Gastrointestinal discomfort, gynecological problems, menopausal symptoms, sleepwalking, seizures,
Major Metabolites: Coumarin glycosides, flavonoids, sesquiterpenoid lactones; eucalyptol, camphor (essential oil; monotorpenes and sesquiterpenes)

Blumea balsamifera (L.) DC. (Asteraceae)
Common Name: Sambong, Ngai camphor
Parts Used: Leaves, stems, roots
DOH Use/s: Treatment of urinary stones; diuretic
Other Use/s: Antibacterial, antifungal, anticancer, antioxidant, antimicrobial, anti-inflammatory, anti-spasm, etc.
Major Metabolites: L-borneol or ngai camphor (monoterpenoids); fatty acids, phenols, sesquiterpenes, flavonoids

Echinacea purpurea (L.) Moench (Asteraceae)
Common Name: Purple Coneflower
Parts Used: Roots and herbs (aerial parts)
Use/s: Respiratory conditions, toothaches, bowel pain, snake bites, skin disorders; anxiety, depression, PTSD, addiction
Major Metabolites: Alkamides, polysaccharides, caffeic acid derivatives

Silybum marianum (L.) Gaertner (Asteraceae)
Common Name: Milk thistle
Parts Used: Achenes, leaves, and roots
Use/s: Liver disorders, gallbladder disorders, digestive system issues
Major Metabolites: Silymarin (flavonoids), fixed oils, sterols

Artemisia annua L. (Asteraceae)
Common Name: Sweet wormwood, sweet annie
Parts Used: Leaves and aerial parts; whole herb
Use/s: Malaria; anti-cancer, antiviral, antiparasitic, anti-inflammatory
Major Metabolites: Artemisinin (sesquiterpenes)

Bacillus licheniformis (Bacillaceae)
Common Name: Bacillus licheniformis
Parts Used: Whole organism; endospore
Use/s: Antimicrobial and antifungal; source of probiotics
Major Metabolites: Bacitracin, lichenysin (non-ribosomal peptides); bacteriocins
Podophyllum peltatum L. (Berberidaceae)
Common Name: Mayapple
Parts Used: Rhizomes and roots; leaves, fruit
Use/s: Warts, precursor for anticancer and antiviral medications; purgative, emetic, anthelmintic
Toxicity: Leaves, unripe fruits, seeds of ripe fruits, and every other part is considered toxic
Major Metabolites: Podophyllotoxin (lignan)

Sinapis alba L. (Brassicaceae)
Common Name: Yellow/White Mustard
Parts Used: Seeds; leaves, flowers (culinary)
Use/s: Respiratory ailments, rubefacient, dental plaque and gum bleeding
Major Metabolites: Sinalbin (isothiocyanate-containing glycoside; glucosinolates)

Rhamphospermum nigrum (L.) Al-Shehbaz (Brassicaceae)
Common Name: Black Mustard
Parts Used: Seeds, stems, roots; leaves (culinary)
Use/s: Anti-microbial (UTIs), anti-oxidant
Major Metabolites: Sinigrin (isothiocyanate-containing glycoside; glucosinolates), alkaloids, flavonoids, phenolics

Brassica napus L. (Brassicaceae)
Common Name: Rapeseed
Parts Used: Seeds (oil); roots, leaves
Use/s: Antioxidant, anti-inflammatory, antidiabetic, anticancer, cardiovascular health
Major Metabolites: Campesterol (phytosterol), sinapic acid (phenolic compounds), sinigrin (glucosinolates)

Ananas comosus (L.) Merr. (Bromeliaceae)
Common Name: Pineapple
Parts Used: Fruit, stem, leaves, peduncle, crown, shoots, and roots
Use/s: Diuretic, sore throat, sea sickness, induce abortion; antimicrobial, antibacterial, anticancer
Major Metabolites: Flavonoids, phenolic compounds, terpenoids, alkaloids; bromelain (enzyme)

Bufo bufo L. (Bufonidae)
Common Name: European toad
Parts Used: Parotoid glands, skin secretions; dried skin, eggs
Use/s: Antitumor/anticancer, cardiotonic, analgesic, anti-inflammatory, anesthetic
Major Metabolites: Bufotoxin, bufalin (bufadienolides), indole alkaloids

Carica papaya L. (Caricaceae)
Common Name: Papaya
Parts Used: Leaves fruit, seeds roots, bark, and latex
Use/s: Digestive disorders, constipation, dengue, fever; anticancer, hypolipidemic, hypoglycemic
Major Metabolites: Carpaine (alkaloids); flavonoids, tannins, saponins, terpenoids, steroids, phenols, cardiac glycosides, anthraquinones

Claviceps purpurea (Fr.) Tul. (Clavicipitaceae)
Common Name: Ergot; Ergot of rye
Parts Used: Sclerotia
Use/s: Induces labor and stops postpartum hemorrhage; migraine treatment, Parkinson’s disease, antitumor
Major Metabolites: Ergotamine, ergometrine (alkaloids)

Garcinia mangostana L. (Clusiaceae)
Common Name: Mangosteen
Parts Used: Roots, fruit rind, edible pulp, bark
Use/s: Diarrhea and dysentery, improves gums and teeth; antioxidant, antimicrobial, antiviral, anti-inflammatory
Major Metabolites: Anthocyanins, benzophenone, condensed tannins; mangostin and gartanin (xanthones)

Combretum indicum (L.) DeFilipps (Combretaceae)
Common Name: Niyog-niyogan
Parts Used: Fruits, seeds, roots, leaf
DOH Use/s: Treatment of ascariasis (intestinal parasite removal)
Other Use/s: Anthelmintic; kidney stones, rheumatism, diarrhea, fever, flatulence
Major Metabolites: Kaempferol, rutin (flavonoids), tannins; flavonoids, phenols, lipids & fixed oils, sterols

Terminalia catappa L. (Combretaceae)
Common Name: Indian almond, wild almond, sea almond, tropical almond, talisay
Parts Used: Leaves, bark, nuts, kernels, whole tree
Use/s: Wound healing, antibacterial, mouth care; analgesic, anti-inflammatory, antimicrobial, antioxidant, antidiabetic, hepatoprotective
Major Metabolites: Hydrolyzable tannins, kaempferol (flavonoids); polyphenols, phytosterols, saponins, phenolic acids

Kalanchoe pinnata (Lam.) Pers. (Crassulaceae)
Common Name: Katakataka, miracle plant
Parts Used: Leaves and roots
Use/s: Kidney stone remedy, wound healing, respiratory relief; antimicrobial, wound healing, anti-inflammatory, anti-diabetic, hepatoprotective, anticancer
Major Metabolites: Bufadienolides, cardenolides (cardiac glycosides); flavonoids, phenolic compounds, tannins, alkaloids, steroids

Conus geographus L. (Conidae)
Common Name: Geography cone snail
Parts Used: Venom
Use/s: Source of the drug Prialt (treats severe chronic pain)
Major Metabolites: ω-, μ-, and α-conotoxins

Chamaecostus cuspidatus (Nees & Mart.) C. Specht & D.W. Stev. (Costaceae)
Common Name: Insulin Plant, fiery costus
Parts Used: Leaves
Use/s: Antidiabetic, antioxidant, anti-inflammatory; stimulant, carminative, diuretic, digestive aid
Major Metabolites: Terpenoids, steroids, flavonoids

Momordica charantia L. (Cucurbitaceae)
Common Name: Ampalaya, bitter melon, bitter gourd
Parts Used: Leaves and fruit
DOH Use/s: Adjunct for non-insulin dependent diabetes mellitus
Other Use/s: Antidiabetic, antioxidant, anti-inflammatory, antimicrobial, anticancer; emetic for newborns
Major Metabolites: Momordicin (alkaloids), charantin (steroidal saponins); phenolic compounds, triterpenoid glycoside, flavonoids

Dioscorea alata L. (Dioscoreaceae)
Common Name: Ube, purple yam
Parts Used: Tuber
Use/s: Irritability, hot flashes, insomnia, and depression; inflammatory and metabolic diseases
Major Metabolites: Diosgenin, dioscin (steroidal saponins); polyphenols, flavonoids, anthocyanins

Ehretia microphylla Lam. (Ehretiaceae)
Common Name: Tsaang-gubat
Parts Used: Leaf
DOH Use/s: Antispasmodic for diarrheal diseases
Other Use/s: Analgesic, antidiarrhea (and general GI discomfort), antispasmodic; prevents tooth decay
Major Metabolites: α-amyrin and β-amyrin (triterpenes); flavonoids, phenolics

Ephedra sinica Stapf. (Ephedraceae)
Common Name: Ma-huang
Parts Used: Stem or aerial parts, roots (rare)
Use/s: Nasal decongestant, bronchodilator (respiratory complaints)
Major Metabolites: Ephedrine (alkaloids); condensed tannins, flavonoids, phenolic acids

Vaccinium myrtoides (Blume) Miq. (Ericaceae)
Common Name: Philippine native blueberry, Ayusip
Parts Used: Fruits, stems, and leaves
Use/s: Relieves fever and inflammation, antidiabetic; antioxidant, immunomodulatory, hepatoprotective
Major Metabolites: Anthocyanins, quercetin (flavonoids); polyphenols, tannins

Arctostaphylus uva-ursi (L.) Spregel (Ericaceae)
Common Name: Bearberry, kinnikkinnick
Parts Used: Dried leaf, berries
Use/s: Diuretic, astringent, UTI antiseptic
Major Metabolites: Arbutin (phenolic/hydroquinone glycosides); tannins, flavonoids, phenolic acids

Vaccinium macrocarpon Aiton (Ericaceae)
Common Name: American cranberry, large cranberry
Parts Used: Fruit, pomace, leaves
Use/s: UTI prevention, antioxidant, cardiovascular health, dental plaque
Major Metabolites: Cinnamtannin B1 (condensed tannins), proanthocyanidins, anthocyanins, flavonols, phenolic acids

Erythroxylum coca Lam. (Erythroxylaceae)
Common Name: Coca plant
Parts Used: Leaves
Use/s: CNS stimulant and local anaesthetic; GI problems, respiratory ailments, altitude sickness
Major Metabolites: Cocaine (alkaloid); tannins, phenols

Euphorbia hirta Linn. (Euphorbiaceae)
Common Name: Tawa-tawa, Gatas-gatas
Parts Used: Whole plant
Use/s: Analgesic, antibacterial, anti-inflammatory, antipyretic, antimalarial, antioxidant; dengue, asthma, snake bites
Major Metabolites: Quercetin, quercitrin (flavonoids); hydrolyzable tannins, phenolic acids, terpenoids

Jatropha curcas L. (Euphorbiaceae)
Common Name: Physic nut, Barbados nut, Tuba-tuba, Tubang-bakod
Parts Used: Leaves, bark, latex, seed, roots
Traditional Use/s: Leaves are heated for back pain relief, rheumatism, muscular pain; pounded leaf/bark poultice for eczema, scabies
Use/s: Anti-inflammatory, antioxidant, antimicrobial, anticancer, antidiabetic; malaria, wounds
Major Metabolites: Flavonoids, tannins, glycosides, diterpenes; phorbol esters

Manihot esculenta Crantz (Euphorbiaceae)
Common Name: Cassava
Parts Used: Tubers (roots), leaves, bark
Use/s: Anti-inflammatory, anti-arthritic, wound-healing and antiseptic, anti-oxidant, digestive aid
Major Metabolites: Amygdalin, linamarin, lotaustralin (cyanogenic glycosides)

Arachis hypogaea L. (Fabaceae)
Common Name: Peanut, mani
Parts Used: Seed/kernel
Pharmaceutical Use/s: Vehicle, emollient
Use/s: Antioxidant, source of vitamin E; oil (confectionary preparations)
Major Metabolites: Fixed oils, stilbenes, isoflavonoid, phenolic acids

Caesalpinia sappan L. (Fabaceae)
Common Name: Brazil or Sappan wood
Parts Used: Heartwood, bark, leaf
Use/s: Extraction of red eye; antioxidant, antibacterial, anti-inflammatory, hypoglycemic, vasorelaxant (anemia, blood circulation), analgesic
Major Metabolites: Flavonoids, anthraquinones, phenolic acids; Brazilin, sappanchalcones, homoisoflavonoids

Cassia fistula L. (Fabaceae)
Common Name: Lombayong (Bis.), golden shower (Eng.)
Parts Used: Leaves, bark, roots, flowers, and fruits
Use/s: Hepatoprotective, anti-inflammatory, antibacterial, antitussive, antifungal, wound healing; asthma, ringworm, laxative
Major Metabolites: Senosides (anthraquinone glycosides); flavonoids, tannins

Clitoria ternatea L. (Fabaceae)
Common Name: Butterfly pea
Parts Used: Flowers, leaves, stems, roots, seeds
Use/s: Memory enhancer, urinary/GI/skin disorders, snake bites; antioxidant, antidiabetic, anti-inflammatory, analgesic, antimicrobial, CNS, anticancer
Major Metabolites: Ternatin (anthocyanins); flavonoids, phenols, glycosides

Entada phaseoloides (L.) Merr. (Fabaceae)
Common Name: Gogo, gugo, St. Thomas bean
Parts Used: Bark, seeds
Use/s: Herbal shampoo, abdominal pain, granular swelling; antioxidant, anti-stress
Major Metabolites: Triterpenoid saponins; flavonoids, tannins, glycosides

Glycyrrhiza glabra L. (Fabaceae)
Common Name: Licorice
Parts Used: Dried roots and stolon
Use/s: Expectorant, soothing, antispasmodic, anti-inflammatory, mild laxative; lung diseases, peptic ulcers
Major Metabolites: Glycyrrhizin (triterpenoid glycosides); flavonoids, coumarins

Leucaena leucocephala (Lam.) de Wit (Fabaceae)
Common Name: White Lead tree, Ipil-ipil
Parts Used: Leaves and seeds
Use/s: Anthelminthic, antibacterial, antidiabetic, antimicrobial, diuretic, antihistaminic, hypocholesterolemic; ascariasis, trichinosis
Major Metabolites: Mimosine (toxic alkaloid); condensed tannins, flavonoids

Glycine soja Siebold et Zuccarini (Fabaceae)
Common Name: Wild soybean
Parts Used: Seeds, aerial parts
Use/s: Anti-inflammatory; antioxidant, anti-aging, antihyperlipidemic, anti-obesity properties, source of lecithin
Major Metabolites: Isoflavonoids, triterpenoids, glycerides

Mimosa pudica Linn. (Fabaceae)
Common Name: Makahiya
Parts Used: Roots and leaves
Use/s: Gastrointestinal, gynecological, skin/blood, systemic diseases; antimicrobial, analgesic, anti-inflammatory, anticonvulsant, antidiarrheal
Major Metabolites: Mimosine (toxic alkaloid); terpenoids, flavonoids, glycosides, phenols, tannins, saponins

Senna alata (L.) Roxb. (Fabaceae)
Common Name: Akapulko, ringworm bush
Parts Used: Flower, root, leaves, seed, and bark
DOH Use/s: Antifungal, antiscabies
Other Use/s: Laxative, diuretic, parturition (childbirth recovery), abortifacient, snake bites; skin diseases, laxative/stimulant cathartic
Major Metabolites: Sennoside A & B (anthraquinone glycosides); tannins, flavanoids, fatty acids, steroids, terpenoids

Cassia angustifolia Vahl (Fabaceae)
Common Name: Alexandrian Senna
Parts Used: Dried leaflets and pods (fruits)
Use/s: Anti-fungal; diabetes, skin hyperpigmentation
Major Metabolites: Senosides A & B (anthraquinone glycosides)

Tamarindus indica L. (Fabaceae)
Common Name: Tamarind, sampalok
Parts Used: Root, stem, fruit, leaf, flowers
Use/s: Antidiabetic, antimicrobial, antivenomous, antioxidant, antimalarial, hepatoprotective, anti-asthmatic
Major Metabolites: Polyphenols, terpenoids, organic acids, fatty acids, tannins

Gliciridria sepium (Jacq.) Kunth ex Walp. (Fabaceae)
Common Name: Madre de Cacao, kakawate
Parts Used: Leaves, flowers, roots
Use/s: Dermatological issues; larvicidal, antimicrobial, antibacterial, anti-inflammatory, inhibitory, mosquito repellent, wound dressing, fumigant, antifungal
Major Metabolites: Flavanols, polyphenolic compounds, essential oils, terpenoids, coumarins

Senegalia senegal (L.) Britton (Fabaceae)
Common Name: Gum Arabic, gum acacia, Senegal gum, three-thorn acacia
Parts Used: Sap (exudate) from stems and branches
Pharmaceutical Use/s: Gum; emulsifier, thickener, tablet binder
Major Metabolites: Gum Arabic

Astragalus gummifer Labill. (Fabaceae)
Common Name: Tragacanth
Parts Used: Dried, gummy exudate from stems and bark
Pharmaceutical Use/s: Gum; emulsifier, thickener, tablet binder
Major Metabolites: Gum Tragacanth

Melilotus officinalis (L.) Lam. (Fabaceae)
Common Name: Sweet yellow clover, yellow melliot
Parts Used: Aerial parts, flowers, leaves
Use/s: Venous insufficiency, edema reduction, anti-inflammatory, analgesic, sedative/antispasmodic
Major Metabolites: Coumarin, melliotin, melilotoside (coumarins; lactone glycosides); flavonoids, phenolic acids

Castanea sativa Mill. (Fabaceae)
Common Name: Sweet chestnut
Parts Used: Leaves, bark/wood, shells (pericarp, integument)
Use/s: Antioxidant, antimicrobial, respiratory issues, anti-inflammatory, anti-cancer
Major Metabolites: Castalagin, vescalagin, castalin (gallotannins); phenolic acids, flavonoids, triterpenes, saponins

Quercus infectoria Oliv. (Fagaceae)
Common Name: Aleppo oak, gall oak
Parts Used: Galls, fruit/acorn hulls
Use/s: Reproductive health (uterine elasticity, leucorrhoea), oral health, GIT disorders, antidiabetic, antiparasitic
Major Metabolites: Gallotannins, phenolic acids, flavonoids

Ginkgo biloba L. (Ginkgoaceae)
Common Name: Ginkgo, maidenhair tree
Parts Used: Leaves, kernels/nuts
Use/s: Improves short-term memory; antioxidant, anti-inflammatory; improves circulation; respiratory diseases, cognitive enhancement
Major Metabolites: Ginkgolides A/B/C (terpene lactones); flavonoids, ginkgolic acids

Psilocybe cubensis (Earle) Singer (Hymenogastraceae)
Common Name: Magic mushroom
Parts Used: Fruiting body (dried)
Use/s: Resistant psychiatric disorders: depression, anxiety, PTSD, addiction; antiviral, anti-inflammatory, antioxidant, antifungal, antibacterial; rituals
Major Metabolites: Psilocybin, psilocin (indole alkaloids)

Hypericum perforatum L. (Hypericaceae)
Common Name: St. John’s wort
Parts Used: Stem, petals, and flowers
Use/s: Antidepressant, CY-P & Pgp inducer
Major Metabolites: Hypericin (anthraquinone glycoside), hyperforin (prenylated phloroglucinols), flavonoids

Karenia brevis (Davis) G. Hansen & Moestrup (Kareniaceae)
Common Name: Red tide, Florida Red tide
Parts Used: N/A
Use/s: N/A
Major Metabolites: Brevetoxin/Brevitoxin (polyether toxins)

Mentha arvensis L. (Lamiaceae)
Mentha X villosa Huds. (Lamiaceae)
Clinopodium douglasii (Benth.) Kuntze (Lamiaceae)
Common Name: Yerba buena, mint
Parts Used: Leaves
Prescribed Use/s: Analgesic
Use/s: Anti-asthmatic (with oregano), antinociceptive, antiseptic, anticancer, diuretic, antispasmodic, antiemintic; indigestion, flatulence, stress, nausea, fainting
Major Metabolites: Carvone, limonene (terpenes), luteolin derivatives (flavonoids), phenolic acids

Mentha cordifolia Opiz ex Fresen (Lamiaceae)
Common Name: Yerba buena, spearmint
Parts Used: Leaves
Prescribed Use/s: Analgesic
Use/s: Pain relief following post-excision biopsy, post-dental extraction, post-episiotomy, and post-circumcision; analgesic, antinociceptive, antiseptic, anticancer, diuretic, antispasmodic, antiemetic
Major Metabolites: Piperitenone oxide, 3-oxygenated monoterpenes, menthalactone (terpenoids), phenolic compounds

Orthosiphon aristatus (Blume) Miq. (Lamiaceae)
Common Name: Cat’s whiskers, Balbas-pusa, Java tea
Parts Used: Leaves
Use/s: Kidney disorders (dysuria, kidney stones, renal inflammation), controlling high blood pressure, rheumatic fever, gout, arthritis, diabetes
Major Metabolites: Sinensetin (flavonoids), rosmarinic acid (phenolics; caffeic acid derivative)

Coleus scutellarioides (L.) Benth. (Lamiaceae)
Common Name: Mayana
Parts Used: Leaves, seeds, bark
Use/s: Anthelmintic, antioxidant, antimicrobial, anti-malarial, potential histamine H4 receptor inhibitor; asthma, angina, bronchitis, epilepsy, insomnia, skin and digestive problems
Major Metabolites: Campesterol (sterols), α-amyrin, β-amyrin (triterpenes), volatile oils

Coleus amboinicus (Lour.) (Lamiaceae)
Common Name: Oregano; Indian Borage, Country borage, Spanish thyme, Mexican mint, French thyme, Indian mint
Parts Used: Leaves; stem, roots, flowers (studied)
Use/s: Expectorant, bronchodilator, anti-inflammatory, carminative, analgesic; fever, headache, inflammation, digestive and skin issues
Major Metabolites: Volatile oils, phenolic acids, flavonoids, triterpenoids, tannins, saponins

Premna odorata Blanco (Lamiaceae)
Common Name: Siargaw, Abgaw kahoy (Bis.), alagaw (Tag.), fragrant premna (Eng.)
Parts Used: Leaves, shoots, fruits, and flowering tops
Use/s: Fever, colds, coughs, bronchitis; sudorific, pectoral, carminative, antimicrobial, antiviral, cardiotonic, anticoagulant, hepatoprotective
Major Metabolites: Terpenes (β-Phellandrene), iridoid glycosides, flavonoids, hydrolyzable tannins, steroids

Vitex negundo L. (Lamiaceae)
Common Name: Lagundi
Parts Used: Dried leaf and flowering top
DOH Use/s: Cough
Other Use/s: Cough, fever, respiratory diseases; anti-inflammatory
Major Metabolites: Luteolin, apigenin (flavonoids), agnuside/negundoside (iridoids), β-caryophyllene (sesquiterpenes), ursolic acid, oleanolic acid (triterpenes); phenylpropanoids/benzenoids

Lavandula spica L. (Lamiaceae)
Common Name: Lavender
Parts Used: Flowering tops; buds, leaves
Use/s: Antiseptic, anti-inflammatory, respiratory benefits, relaxation (scent), analgesic
Major Metabolites: Linallyl acetate, camphor, linalool, lavandulol (monoterpenes)

Lagerstroemia speciosa (L.) Pers. (Lythraceae)
Common Name: Crepe Myrtle (English); banaba (Tagalog)
Parts Used: Leaves
Use/s: Anti-diabetic, anti-obesity, anti-cancer, antioxidant, antibacterial, anti-inflammatory, analgesic, anti-hepatic steatosis, anti-ulcerative colitis, anti-cariogenic, and anti-HIV
Major Metabolites: Lagerstroemin (ellagitannins), corosolic acid (triterpenes), quercetin-type flavonoids, phenolic acids

Punica granatum L. (Lythraceae)
Common Name: Pomegranate, Granada
Parts Used: Fruit (arils and peel), bark, leaves, roots
Use/s: Antioxidant, antimicrobial, anti-inflammatory, and cardioprotective, astringent; diarrhea, ulcers, infections
Major Metabolites: Punicalagin (ellagitannin), ellagitannins; anthocyanins, quercetin-type flavonoids (flavonoids), hydrolyzable tannins

Banisteriopsis caapi Spruce ex Griseb. C.V. Morton. (Malpighiaceae)
Common Name: Ayahuasca or Yajé
Parts Used: Leaves, bark
Use/s: Psychedelic (used in decoctions and infusions to induce psychoactive effects); religious ceremonies of indigenous tribes
Major Metabolites: Harmine, harmaline, tetrahydroharmine (alkaloids)

Abelmoschus esculentus (L.) Moench (Malvaceae)
Common Name: Okra, Lady’s fingers
Parts Used: Immature fruit pods, leaves
Use/s: Diuretic, dental disease, gastric irritations; demulcent, antioxidant, anti-inflammatory, anti-cancer
Other Use/s: Improves texture in dishes, supports digestive health
Major Metabolites: Quercetin and kaempferol derivatives (flavonoids), phenolic compounds, phytosterols, terpenoids, tannins, mucilage and pectin (polysaccharides)

Hibiscus rosa-sinensis L. (Malvaceae)
Common Name: Gumamela, China rose
Parts Used: Flowers, stems, roots, leaves
Use/s: Fever, inflammation, bacterial infections, contraceptive agent; antitumor, antioxidant, antifungal, antimicrobial, analgesic, antipyretic, anti-asthmatic, anti-inflammatory
Major Metabolites: Flavonoids, phenolic compounds, glycosides/glucosides, saponins, phytosterols, terpenoids

Theobroma cacao L. (Malvaceae)
Common Name: Cacao, cocoa
Parts Used: Seeds (cacao beans), seed fat (cocoa butter)
Use/s: Stimulant, antioxidant, cardiovascular health; support digestion and well-being
Major Metabolites: Theobromine, caffeine (alkaloids); catechins, epicatechins (flavonoids), proanthocyanidins (tannins)

Lytta vesicatoria L. (Meloidae)
Common Name: Spanish Fly
Parts Used: Whole body
Use/s: Burns, scalds, inflammations of the skin and mucous membranes, UTIs
Major Metabolites: Cantharidin (terpenoids)

Tinospora crispa L. (Menispermaceae)
Common Name: Makabuhay, Heart-leaved moonseed
Parts Used: Stems (primarily), leaves
Use/s: Fever, diabetes, digestive disorders; anti-inflammatory, antimalarial, immune-boosting
Major Metabolites: Alkaloids, diterpenoids, glycosides, flavonoids, phenolic compounds

Chondrodendron tomentosum Ruiz & Pav. (Menispermaceae)
Common Name: Uva de montana (Mountain grape), curare vine
Parts Used: Fruit, pericarp, bark and roots
Use/s: Arrow poison, sustenance; antioxidant, anti-inflammatory, anticancer, surgical skeletal muscle relaxant
Major Metabolites: Cyanidin-3-glucosides (flavonoids, anthocyanins), ascorbic acid (phenols), D-tubocurarine (alkaloids)

Moringa oleifera Lam. (Moringaceae)
Common Name: Malunggay
Parts Used: Leaves, root, bark, flowers, seeds, stalks
Use/s: Galactagouge; antimicrobial, antifungal, anti-inflammatory, antioxidant, anticancer, fertility, wound-healing
Major Metabolites: Sinapic acid, gallic acid, ferulic acid (phenolic compounds), D-mannose (carbohydrate)

Psidium guajava L. (Myrtaceae)
Common Name: Guava (Eng.), bayabas (Ilk., Tag.)
Parts Used: Leaves, bark, fruit, flowers, roots
DOH Use/s: General antiseptic; tooth decay and gum infection
Other Use/s: Wound healing, antidiabetic, antihypertensive, anticancer; gastrointestinal infections, malaria, respiratory, oral, dermal infections
Major Metabolites: Quercetin, guiajavarin (flavonoids), triterpenods, sesquiterpenes, glycosides, phenolics/polyphenols, saponins, alkaloids, meroterpenoids

Syzygium cumini (L.) Skeels (Myrtaceae)
Common Name: Jambolan, black plum, duhat
Parts Used: Leaves, stem bark, flowers, roots, fruits
Use/s: Cough, diabetes, dysentery, inflammation, ringworm
Major Metabolites: Anthocyanins, flavonoids, phenolic compounds, glycosides, alkaloids

Syzygium aromaticum (L.) Merr. & L.M. Perry (Myrtaceae)
Common Name: Clove
Parts Used: Dried flower buds (cloves), essential oil, fruit
Use/s: Analgesic, antiseptic (dental health), antimicrobial, antioxidant, antifungal
Major Metabolites: Eugenol, isoeugenol (phenylpropenes); flavonoids, phenolic acids, tannins

Jasminum sambac (L.) Aiton (Oleaceae)
Common Name: Arabian Jasmine (English); Sampaguita (Tagalog)
Parts Used: Flowers, leaves, roots
Use/s: Breast cancer; anti-lactation, spasmolytic, anti-inflammatory, antimicrobial, antiulcer, antioxidant, cytoprotective, chemopreventive, wound healing
Major Metabolites: Iridoidal glycosides, aromatic glycosides, triterpenes, sterols, flavonoids, long-chain aliphatic compounds, volatile compounds

Olea europaea L. (Oleaceae)
Common Name: Olive
Parts Used: Fruit oil, leaves
Use/s: Hypoglycemic, cholesterol and uric acid lowering; cardioprotective, antioxidant, anti-inflammatory
Major Metabolites: Oleuropein, hydroxytyrosol (phenolic secoiridoids), phenolic compounds, fatty acids

Vanilla planifolia Andrews (Orchidaceae)
Common Name: Vanilla, vanilla orchid
Parts Used: Pods (fruits/beans); leaves, stems, flowers
Use/s: Antioxidant, antimicrobial, sedative/anxiolytic (scent)
Major Metabolites: Vanillin (aldehyde-containing glycosides); phenolic compounds, flavonoids

Averrhoa bilimbi L. (Oxalidaceae)
Common Name: Bilimbi/Kamias
Parts Used: Leaves, fruit
Use/s: Diabetes mellitus, hypertension, antimicrobial; antidiabetic, thrombolytic, antioxidant, hepatoprotective, anthelminthic, hypolipidemic
Major Metabolites: Flavonoids, phenolic compounds, tannins, (cardiac) glycosides, triterpenes; saponins, alkaloids, carbohydrates

Pandanus amaryllifolius Roxb. (Pandanaceae)
Common Name: Pandan
Parts Used: Leaves
Use/s: Headaches, fever, arthritis, inflammation; antioxidant, analgesic, antidiabetic, antimicrobial; food flavoring
Major Metabolites: Heterocyclic aromatic compounds, terpenes, flavonoids, tannins, alkaloids, sterols
